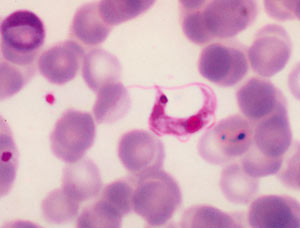
Figur 2  Trypanosoma cruzi i perifert blod. Foto LL Moore, Public Health Image Library, CDC, USA

På det søramerikanske subkontinent lever i dag omkring 20 millioner mennesker med Chagas’ sykdom (1, 2). Årlig dør ca. 50 000 av disse pga. hjerteaffeksjon (2). I endemiske områder er Chagas’ kardiomyopati den vanligst forekommende ikke-koronare hjertesykdom, og den hyppigste hjertedødsårsak hos barn og unge. Med økt mobilitet i verdens befolkning, er det anslått at mer enn 300 000 infiserte pasienter lever utenfor endemiske områder, hovedsakelig i USA og Europa (1). Sykdommen er foreløpig sjelden i Skandinavia og finnes i praksis kun blant innvandrere fra endemiske områder. Hos slike innvandrere må Chagas’ sykdom imidlertid overveies som mulig årsak til uklare kardiale og gastrointestinale sykdomstilstander.
Materiale og metode
Artikkelen gir en oversikt over aktuelle problemstillinger relatert til Chagas’ sykdom, med utgangspunkt i en kasuistikk fra Haukeland Universitetssjukehus. Litteratursøk med søkeord «Chagas’ disease», «diagnosis»,» therapy», «pregnancy», «delivery» er gjort i Cochrane Library og Medline, begrenset til engelskspråklige artikler. Av den omfattende litteratur som foreligger, har vi etter klinisk skjønn valgt ut litteraturen som ligger til grunn for denne artikkelen mht. hva som ble ansett som mest relevant og interessant for Tidsskriftets lesere.
Pasienten er en kvinne født i 1948, oppvokst i Brasil, i området hvor Carlos Chagas først oppdaget sykdommen og hvor den fremdeles er hyperendemisk. Hun er norsk gift og har bodd i Norge fra slutten av 1970-årene. Alle hennes fire barn, hvorav tre er født i Norge, er friske. Kvinnen er arvelig belastet med henblikk på koronarsykdom. Det er opphopning av Chagas’ sykdom i nær familie, med en søster som er asymptomatisk seropositiv for T cruzi, en fetter som i 30-årsalderen utviklet alvorlig gastrointestinal Chagas’ sykdom med lungekomplikasjoner, med bedring etter gastrointestinal kirurgi og lungereseksjon, samt en av fars brødre som døde 35 år gammel etter et tre måneders sykdomsforløp forenlig med Chagas’ myokarditt. Vår pasient var stort sett frisk inntil hun høsten 2003 utviklet moderat anstrengelsesrelatert dyspné og brystsmerter, men hun gikk på arbeid som vanlig og søkte ikke lege. Fra november økende symptomer, og i desember 2003 ble hun akutt innlagt i lokalsykehus med brystsmerter og hjertebank. Hun hadde fått lidokain av innleggende lege. EKG ved innkomst viste ventrikkeltakykardi med frekvens 200/min. Hun fikk initialt intravenøs støtdose med amiodaron uten tilstrekkelig effekt, hvoretter hun ble elektrokonvertert. Etter konverteringen viste EKG sinus- og AV-knutebradykardi med ventrikkelfrekvens ned på 30-tallet, og pasienten ble overført til Haukeland Universitetssjukehus til vurdering for pacemakerbehandling.
Ved ankomst universitetssykehuset viste EKG langsom sinusrytme og AV-knuterytme, konstant høyre grenblokk og intermitterende AV-blokk grad II. Røntgen thorax: moderat til uttalt forstørret, venstrekonfigurert hjerte. Ekkokardiografi: dilatert venstre ventrikkel (6,9/4,8 cm), hypokinesi basalt i nedre vegg, ejeksjonsfraksjon 0,53, ingen klaffefeil av betydning. Koronar angiografi: normale koronararterier. Elektrofysiologisk undersøkelse: lett induserbar, vedvarende, monomorf ventrikkeltakykardi, brutt med kortvarig rask atriestimulering (burst pacing), og man konkluderte med at implanterbar cardioverter-defibrillator (ICD) syntes indisert.
Av grunner som ikke fremgår av journalen, ble imidlertid ICD ikke ytterligere overveid. I stedet ble det implantert en konvensjonell tokammerpacemaker. Pasienten ble kort tid etter utskrevet i velbefinnende med acetylsalisylsyre, metoprolol og simvastatin. Ved poliklinisk pacemakerkontroll i mai 2004 var forholdene tilfredsstillende, og pulsgeneratorens telleverk viste 98 % tokammerpacing.
I oktober 2004 mottok Haukeland Universitetssjukehus en forespørsel fra pasientens reiseforsikringsselskap. Under ferieopphold i hjemtraktene i Brasil sommeren 2004 hadde pasienten på ny fått ventrikkeltakykardi. Hun ble elektrokonvertert i lokalsykehus, og amiodaronbehandling ble startet. Chagas’ sykdom ble verifisert serologisk ved sterk positivitet i ELISA med rekombinante T cruzi-antigener (OD 1,61, normalt < 0,20) ved regional kardiologisk avdeling (Instituto CárdioPulmonar, Laboratório de Patologia Clínica, Salvador, Brasil). Pulsgeneratoren ble fjernet og ICD (Medtronic Gem III DR 7275) implantert.
Pasienten har ikke hatt symptomgivende arytmiepisoder etter dette, men hun er sykmeldt pga. funksjonsdyspné. Ved poliklinisk kontroll i juni 2006 hadde hun ren pacemakerrytme og dårlig egenrytme med flere sekunders asystoli ved pacemakerhemning. Det er ikke registrert takyarytmiepisoder ved avlesning av ICD-en. Hun behandles med kaptopril, karvedilol, aldactone og warfarin. Amiodaron er seponert.
Smitteoverføring
Chagas’ sykdom, eller amerikansk trypanosomiasis, forårsakes av den encellede parasitten Trypanosoma cruzi. Sykdommen er en zoonose med reservoar i over 150 pattedyr, inkludert hund og katt. Smitten overføres gjennom blodsugende teger (fig 1). Tegene, som helst biter om natten, holder ofte til i sprekker i dårlige hus bygd av gress og leire, og sykdommen er følgelig mest utbredt i den fattige del av befolkningen. Infiserte teger deponerer parasittholdig avføring når de suger blod. Smitte skjer ved at parasittene klores inn i huden ved bittutløst kløe, eller ved direkte invasjon av slimhinner i conjunctiva, nese og munn. Andre viktige smittemåter i endemiske områder er smitte fra mor til barn ved svangerskap og fødsel og transfusjonsassosiert smitte, som også er de vanligste smittemåter utenfor endemisk område. T cruzi kan også overføres ved organtransplantasjon fra infisert giver. Utbrudd knyttet til inntak av næringsmidler er beskrevet og skyldes sannsynligvis at infiserte teger har kontaminert produksjonsprosessen. Risikoen for smitte ved kortvarige besøk i endemiske områder er ubetydelig.

Sykdommen har fått navn etter den brasilianske legen Carlos Ribeiro Chagas (1879 – 1934). Han påviste i 1909 trypanosomer i teger i forbindelse med undersøkelser av «atypisk malaria» i delstaten Minas Gerais i Nordøst-Brasil. Sikker assosiasjon til human sykdom ble først påvist i 1911 da Chagas isolerte parasitten fra et barn med feber, anemi og lymfadenopati. Chagas navnga trypanosomen etter sin mentor og venn, den internasjonalt anerkjente brasilianske lege og epidemiolog Oswaldo Cruz (1872 – 1917). Tegene og deres bittmønster ble detaljert beskrevet av Charles Darwin 25. mars 1835 i et dagboksnotat fra reisen med Beagle (3). Han ble bitt en rekke ganger, og det har vært spekulert i om Darwin selv døde av Chagas’ kardiomyopati.
Akutte sykdomsmanifestasjoner
Primærinfeksjonen med T cruzi er vanligst hos barn og oftest asymptomatisk. 10 – 20 % av de smittede viser et uspesifikt febrilt sykdomsbilde og bare 5 % utvikler «klassisk» myokarditt eller meningoencefalitt. Parasitten formerer seg ved bittstedet og kan gi lokalt ødem, såkalt chagom. Hvis inngangsporten er i conjunctiva eller ved øyet, kan man se det nærmest patognomoniske Romañas tegn med ødem av øyelokk og periorbitalt. Ved hematogen spredning kan myokard, autonome nervepleksuser og sentralnervesystemet infiseres. I akuttfasen kan T cruzi påvises i vanlig blodutstryk (fig 2) eller tykkdråpe og vil oftest vokse på standard isolasjonsmedier. Ubehandlet dør 5 – 10 % av pasientene med myokarditt eller meningoencefalitt i denne fasen (1). Den totale dødelighet i akuttfasen er således relativt lav. Ved kongenitt Chagas’ sykdom mangler lokale inokulasjonstegn, men ca. 45 % har uspesifikke symptomer og tegn som hepatosplenomegali, icterus, hudblødninger og nevrologiske utfall (1, 4).
Kroniske sykdomsmanifestasjoner
Noen måneder etter smitte kan ikke parasitten lenger påvises i blod. Et mindretall av de smittede klarer å eliminere infeksjonen og bli seronegative. Men hos de fleste går sykdommen inn i asymptomatisk fase med persisterende seropositivitet. Parasittene finnes da intracellulært som amastigote former i pseudocyster i hjertemuskulatur (fig 3), nervepleksuser i gastrointestinaltractus og urinveier, og i sentralnervesystemet. Denne fasen kan vare 10 – 30 år, eller hele livet, uten at pasienten utvikler symptomer. 15 – 40 % av de kronisk infiserte vil imidlertid utvikle kronisk symptomgivende Chagas’ sykdom 10 – 20 år etter primærinfeksjon (5). Det ses to klassiske sykdomsmanifestasjoner, hvorav kardiomyopati med rytmeforstyrrelser er den absolutt viktigste. Megasyndromer ses også, fordi T cruzi kan destruere parasympatiske nervepleksuser i gatrointestinaltractus og, sjeldnere, i urinveiene. Megaoesophagus manifesterer seg med dysfagi og aspirasjonspneumonier, mens megacolon kan gi intraktabel obstipasjon. Megasyndromer ses nesten utelukkende sør for Amazonas, sannsynligvis pga. speciesforskjeller blant T cruzi. Samtidig myokardaffeksjon er vanlig. Ved kronisk infeksjon vil ca. 90 % av pasientene være T cruzi-positive i PCR-metodikker, som imidlertid kun er tilgjengelig i spesiallaboratorier (ramme 1). Diagnostikken baserer seg normalt på serologi i form av immunfluorescens eller ELISA-tester med ulike rekombinante T cruzi-antigener. Mikroskopisk undersøkelse hos kronikere er hensiktsløst pga. ekstremt lavgradig parasittemi.

Laboratorier som etter avtale vil kunne være behjelpelige med T cruzi-diagnostikk
Serologiske undersøkelser
Smittskyddsinstitutet (SMI)
17182 Solna, Sverige
Tlf. 0084572300
Hjemmesiden www.smi.se har utførlig informasjon om prøvetaking etc.
Både serologisk og PCR-basert diagnostikk
Drs. Anne Moore og Frank Steurer
Division of Parasitic Diseases
Centers for Disease Control and Prevention , Atlanta, USA.
e-post: aym2@cdc.gov og fjs1@cdc.gov
Tlf. 00 1 770 488 7776
Faks 770 488 7761
Michel Tibayrenc
e-post: Michel.Tibayrenc@mpl.ird.fr
Institut de Recherche pour le Développement (IRD),
CNRS (Centre National de la Recherche Scientifique)-IRD no 2724,
911 Avenue Agropolis
BP 64501
34394 Montpellier cedex 5, France
Immunsuppresjon og Chagas’ sykdom
Immunsupprimerende behandling med cytostatika eller steroider, kan gi reaktivering av latent Chagas’ sykdom med alvorlig myokarditt og nekrotiserende meningoencefalitt. Ved hivindusert immunsvikt ses også chagomer som intracerebrale tumorliknende prosesser.
Kardiologiske aspekter
Som kasuistikken viser, vil leger som praktiserer i Norge, kunne støte på pasienter med Chagas’ sykdom i kronisk stadium. Pasientene vil kunne ha kardiologiske og, en sjelden gang, gastroenterologiske manifestasjoner. De kardiologiske problemstillingene dominerer. Longitudinelle studier viser at tilstanden hos 2 % av asymptomatiske seropositive smittede årlig progredierer til kardial Chagas’ sykdom (1). Sykdommen debuterer oftest med arytmier. Autonom denervering av hjertet kan føre til sinoatriale og atrioventrikulære ledningsforstyrrelser. Grenblokk er vanlig, særlig høyre grenblokk som ofte er kombinert med venstre fremre hemiblokk. Komplekse ventrikulære arytmier ses svært ofte og hos 80 – 90 % av pasientene kan ventrikulære takykardier utløses ved elektrofysiologisk undersøkelse (6). Over tid utvikles kongestiv kardiomyopati med karakteristiske apikale aneurismer som oftest er mest uttalt i høyre ventrikkel. Intrakardiale tromber ses ofte (7).
Dødsårsaken hos voksne pasienter er i 55 – 65 % av tilfellene plutselig død, oftest etter fysisk anstrengelse som kan antas å ha utløst en ventrikulær takyarytmi. Andre vanlige dødsårsaker er kronisk uni- eller biventrikulær hjertesvikt samt kardiogene embolier til lunge- eller systemisk kretsløp.
Pasienter med arytmier av enhver art og/eller kardiomegali skal ha livslang antikoagulasjonsbehandling. Hjertesvikt behandles med vanlige medikamenter.
De største medisinske utfordringer ligger i håndteringen av arytmiene. Når en pasient først har fått arytmi, vil denne vanligvis opptre så hyppig at den registreres i vanlig EKG eller i 24-timers-EKG. Ved anamnestiske holdepunkter for arytmi som ikke lar seg lett verifisere, anbefales registrering over flere døgn. Arbeids-EKG kan også være aktuelt.
Ved valg av antiarytmisk medikamentell behandling foretrekkes amiodaron. Man har imidlertid ikke sikre holdepunkter for at amiodaron eller andre antiarytmika bedrer overlevelsen, spesielt ikke ved venstre ventrikkel-svikt.
Implantasjon av ICD hos Chagas-pasienter, resuscitert etter ventrikulære arytmier, er i en nylig publisert studie vist å gi en dramatisk overlevelseseffekt etter observasjontider på 1 – 6 år (8). Dette gjelder også pasienter uten venstre ventrikkel- dysfunksjon. Flertallet av pasientene blir ICD-avhengige, og over 90 % trenger ICD-utløst antitakykardipacing eller elektrosjokk i løpet av det første året etter implantasjonen. Da de fleste pasientene med arytmiproblemer har hjertesvikt, eller vil utvikle dette i løpet av få år, er det grunn til å velge en ICD med resynkroniseringmodus (atriobiventrikulær pacing). Resynkroniseringsbehandling alene har vist seg å være utilstrekkelig. (9).
Seleksjon av pasienter til elektrofysiologiske undersøkelser med tanke på eventuell ICD-behandling er vanskelig. Høyre grenblokk, særlig kombinert med venstre fremre hemiblokk og eventuelt atrioventrikulært blokk, er et dårlig prognostisk tegn mht. livstruende ventrikulære arytmier. Chagas’ kardiomyopati er i endemiske områder de fattiges hjertesykdom, og elektrofysiologisk undersøkelse vil kun være tilgjengelig for et fåtall pasienter. I Skandinavia bør enhver pasient med mistenkt Chagas’ sykdom og påvist eller mistenkt arytmi eller blokkering henvises til elektrofysiologisk utredning. Det samme gjelder ved opplysninger om synkope/nærsynkope. En nylig publisert artikkel om beregning av risikoskår kan være til hjelp i vurderingen av den enkelte pasients prognose (10).
Smitteoverføring ved svangerskap og fødsel
Transplacental eller perinatal overføring av T cruzi fra kronisk infisert seropositiv mor forkommer ved 2 – 8 % av fødsler (11). Kongenitt Chagas’ sykdom i Skandinavia ble første gang beskrevet for 25 år siden (12). Over 90 % av mor-barn-smitten skjer intrauterint, og barnet fødes med parasittemi. Navlestrengsblod må undersøkes umiddelbart etter fødselen, da T cruzi er svært fragil og kan lysere innen 1 – 2 timer (ramme 2).
Undersøkelser ved mulig T cruzi-smitte fra mor til barn
Undersøkelse av navlestrengsblod – innen 1 time etter fødsel
-
Buffycoat fra 4 x 50 µl mikrorør undersøkes med
direkte mikroskopi for levende trypanosomer
giemsafarging
2 ml navlestrengsblod til dyrking på Novy-Mac Neal-Nicolle-medium
1 ml navlestrengsblod til polymerasekjedereaksjon (PCR) for T cruzi
Hvis kun positiv på PCR – nye prøver straks, OBS falskt positivt PCR?
Hvis negative prøver – nye prøver etter 4 – 6 uker eller før
Barn som smittes under selve fødselen, vil ikke ha parasitter i navlestrengsblodet, men vil utvikle parasittemi i løpet av første levemåned. Undersøkelse av venøst blod må utføres etter 4 – 6 uker, uansett klinisk tilstand, for å avdekke asymptomatisk perinatal smitte. Spesifikt serum-IgM mot T cruzi er uten verdi ved diagnostikk av perinatal Chagas’ sykdom. Prenatal diagnostikk av navlestrengsblod kan påvise T cruzi ved klinisk mistanke (13).
Tidlig medikamentell behandling kan forhindre alvorlig, potensielt livstruende akutt sykdom hos nesten alle nyfødte, og forhindrer utvikling av kronisk infeksjon hos opptil 70 – 95 %. Behandlingen er benznidazol 10 mg/kg peroralt i 60 døgn i form av knuste tabletter løst i morsmelk eller medisinsk sirup. Alvorlige bivirkninger ses sjelden. Medikamentet må være tilgjengelig ved fødsler hvor barnet kan være infisert. T cruzi-seropositive gravide må føde på sykehus med spisskompetanse. Amming frarådes ikke (14).
Vi har ved Haukeland Universitetssjukehus fulgt to kvinner med kronisk Chagas’ sykdom, verifisert ved indirekte immunfluorescenstest utført ved Department of Parasitic Diseases ved Centers for Disease Control and Prevention, Atlanta, USA (DPD-CDC). Disse har samlet født seks barn. Sera fra fem av disse var tilgjengelig for testing for T cruzi- antistoff ved DPD-CDC. Antistoff kunne ikke påvises etter spedbarnsperioden, og barna regnes derfor som ikke infiserte.
Bloddonasjon/organtransplantasjon/adopsjon
Personer født utenfor Norden aksepteres ikke som blodgivere eller organdonorer i Norge. Dette utelukker i praksis transfusjonsassosiert og donorassosiert smitte. Imidlertid vil nye regler, som er under forberedelse, sannsynligvis innebære at personer som er fra, eller har fått blodoverføring i, områder hvor Chagas’ sykdom er endemisk, men som ikke selv har hatt sykdommen, vil kunne godtas som blodgivere hvis validert test for T cruzi er negativ og personen har bodd minst seks måneder i Norge (Blodbanken, Haukeland Universitetssjukehus, personlig meddelelse). Ettersom latent Chagas´ sykdom kan aktiveres ved immunsuppressiv terapi, må transplantasjonsresipienter fra endemisk område undersøkes for antistoffer mot T cruzi. Antistoffscreening kan også være aktuelt ved adopsjon av barn fra endemisk område (15), men nasjonale retningslinjer for dette foreligger ikke.
Medikamentell behandling av Chagas’ sykdom
Chagas’ sykdom i akuttfasen kan behandles med medikamentene nifurtimox eller benznidazol. Pga. manglende eller uspesifikke symptomer ved flertallet av primærinfeksjoner, forløper disse oftest udiagnostisert og ubehandlet. Medikamentell behandling i senere sykdomsstadier er omdiskutert. De aktuelle medikamenter har liten eller ingen effekt hos voksne i latent eller kronisk fase. Behandling av barn og ungdom med Chagas’ sykdom i latent fase har imidlertid effekt. I en studie ble det funnet 85 % helbredelse, definert som seronegativitet seks år etter, i gruppen som gjennomførte behandling i 60 dager med benznidazol, mot 26 % i placebogruppen (16). Denne og andre studier har ført til at WHO og Pan-American Health Organization nå anbefaler behandling av seropositive barn og unge i latent fase. Seropositive adoptivbarn kan således være behandlingskandidater. Behandling i kronisk fase er symptomatisk.
Nye medikamenter mot T cruzi er under utvikling. Spesiell oppmerksomhet er rettet mot at både sopp og trypanosomer har essensiell ergosterolsyntese som hemmes av azoler. Antiarytmikumet amiodaron er også nylig vist å ha antitrypanosomal effekt på T cruzi via endringer i parasittenes kalsium homøostase, og stoffet hemmer også ergosterolsyntesen (17). Synergisme mellom amiodaron og azolet posaconazol er påvist in vitro og in vivo (17). Nyere azolforbindelser og andre lovende substanser er under utvikling.
Konklusjon
Hos pasienter fra endemisk område må Chagas’ sykdom vurderes ved ikke-koronar hjertesykdom og arytmier. Rytmeforstyrrelsene kan være livstruende. ICD, oftest med biventrikulær pacing, vil være indisert hos mange pasienter. Livslang antikoagulasjonsbehandling er påkrevet. Gravide fra endemiske områder bør testes for antistoff mot T cruzi og følges opp ved spesialavdeling. Testing av adoptivbarn bør vurderes. Organtransplantasjon, immunsuppresjon og hivimmunsvikt reiser komplekse problemstillinger hos pasienter som er seropositive for T cruzi pga. fare for livstruende reaktivering av Chagas’ sykdom.
Vi takker DPD-CDC ved dr. Anne Moore og Frank Steurer for sjenerøs bistand i form av testing av sera, velvillig hjelp ved utarbeiding av retningslinjer for diagnostikk og behandling av perinatal T cruzi-infeksjon og illustrasjonsfoto til artikkelen.
Oppgitte interessekonflikter: Ingen
Tabell
| Hovedbudskap |
|
- 1.
Prata A. Clinincal and epidemiological aspects of Chagas disease. Lancet Infect Dis 2001; 1: 92 – 100.
- 2.
Ceaser M. Battling with Chagas disease in South America. Lancet Infect Dis 2005; 5: 470 – 1.
- 3.
Darwin C. Journal of researches (chapt. 15). London 1839. www.literature.org/authors/darwin-charles/the-voyage-of-the-beagle/chapter-15.html (8.7.2006).
- 4.
Torrico F, Alonso-Vega C, Suarez E et al. Maternal Trypanosoma Cruzi infection, pregnancy outcome, morbidity and mortality of congenitally infected and non-infected newborns in Bolivia. Am J Trop Med Hyg 2004; 20: 201 – 9.
- 5.
Lalloo D. South American trypanosomiasis (Chagas Disease). I: Gill G, Beeching NJ, red. Lecture notes on tropical medicine. 5. utg. Boston: Blackwell Publishing, 2004: 127 – 8.
- 6.
Elizari MV. Arrhythmias associated with Chagas’ heart disease. Card Electrophysiol Rev 2002; 6: 115 – 9.
- 7.
Rossi MA. Comparison of Chagas’ heart disease to arrhythmogenic right ventricular cardiomyopathy. Am Heart J 1995; 129: 626 – 9.
- 8.
Cardinalli-Neto A, Greco OT, Bestetti RB A. Automatic implantable cardioverter-defibrillators in Chagas heart disease patients with malignant ventricular arrhytmias: PACE 2006; 29: 467 – 70.
- 9.
DaSilva Menezes. Outcome of right ventricular bifocal pacing in patients with permanent atrial fibrillation and severe dilated cardiomyopathy due to Chagas disease: three years of follow-up. J Interv Card Electrophys 2002; 11: 193 – 8
- 10.
Rassi A jr., Rassi A, Little W et al. Development and validation of a risk score for predicting death in Chagas’ disease. N Engl J Med 2006; 355: 799 – 808.
- 11.
Agrelo RS. American trypanosomisis (Chagas disease). I: Heymann DL, red. Control of communicable diseases manual. 18. utg. Washington, D.C.: American Public Health Association, 2004: 557 – 60.
- 12.
Pehrson P-E, Wahlgren M, Bengtsson E. Asymptomatic congenital Chagas disease in a 5 year-old child. Scand J Infect Dis 1981; 13: 307 – 8.
- 13.
Okumura M, Aparecida dos Santos V, Camargo ME et al. Prenatal diagnosis of congenital Chagas’ disease (American trypanosomiasis). Prenat Diagn 2004; 24: 179 – 81.
- 14.
Bittencourt AL, Sadigursky M, Da Silva AA et al. Evaluation of Chagas’ disease transmission through breast-feeding. Mem Inst Oswaldo Cruz 1988; 83: 37 – 9.
- 15.
Pehrson P-E, Wahlgren M, Bengtsson E. Intracranial calcifications probably due to congenital Chagas disease. Am J Trop Med Hyg 1982; 31: 449 – 51.
- 16.
Andrade AL, Martelli CM, Oliveira RM et al. Short report: Benznidazol efficacy among Trypanosoma Cruzi-infected adolenscents after a six-year follow-up. Am J Trop Med Hyg 2004; 71: 594 – 7.
- 17.
Benaim G, Sanders JM, Garcia-Marchan Y et al. Amiodarone has intrinsic anti-trypanosoma cruzi activity and acts synergistically with posaconazole. J Med Chem 2006; 49: 892 – 9.